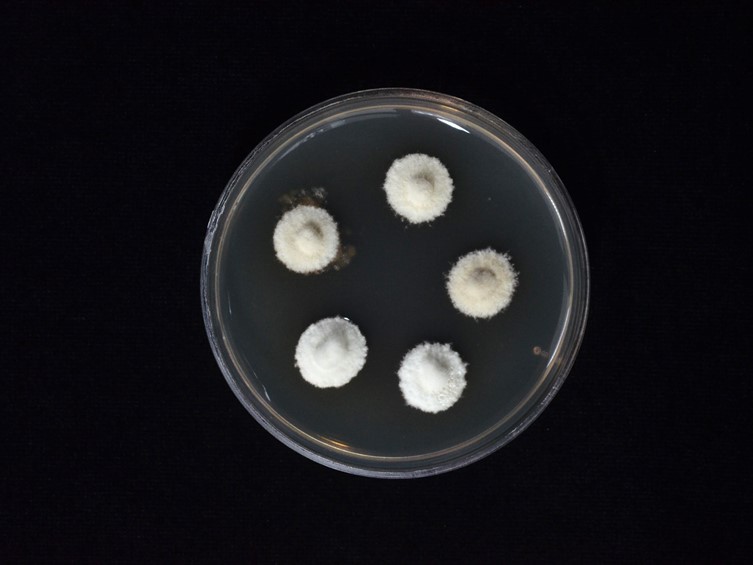

Holotype:
THAILAND, Buri Ram Province, Dong Yai Wildlife Sanctuary, 10 Dec. 2010, K. Tasanathai, P. Srikitikulchai, A. Khonsanit, K. Sansatchanon, W. Noisripoom, A. Saksrikrom, B. Saracam, S. Mongkolsamrit, holotype BBH 38545, ex-type living culture BCC 45574.
Habitat:
Underside of a dicotyledonous leaf.
Host:
On Theridiidae.
Description:
Yellow mycelia fully covering the  spider body, occasionally on its legs.
spider body, occasionally on its legs.  Synnemata brownish white in a group of three, cylindrical, attenuated, 7 mm long, 175 µm wide, narrowing to a slender apex, terminating into a swollen tip.
Synnemata brownish white in a group of three, cylindrical, attenuated, 7 mm long, 175 µm wide, narrowing to a slender apex, terminating into a swollen tip.  Conidiophores scattered, arising from the outer layer of synnemata and the mycelia somewhat loosely attached to the host body and legs, multiseptate, verrucose, 62.5–180 × 7.5–10 µm, becoming shorter towards the tip of synnemata, tapering abruptly to a distinct neck, enlarging into a vesicle. Vesicle globose to subglobose, 6.5–8.5 µm diam, bearing a group of metulae. Metulae broadly obovoid, 6.5–8 × 5–7 µm.
Conidiophores scattered, arising from the outer layer of synnemata and the mycelia somewhat loosely attached to the host body and legs, multiseptate, verrucose, 62.5–180 × 7.5–10 µm, becoming shorter towards the tip of synnemata, tapering abruptly to a distinct neck, enlarging into a vesicle. Vesicle globose to subglobose, 6.5–8.5 µm diam, bearing a group of metulae. Metulae broadly obovoid, 6.5–8 × 5–7 µm.  Phialides borne on metulae, narrowly clavate to cylindrical, 6–7.5 × 2–2.5 µm, each bearing a conidium. A vesicle, metulae and phialides forming a spherical conidial head, 30–33 µm diam.
Phialides borne on metulae, narrowly clavate to cylindrical, 6–7.5 × 2–2.5 µm, each bearing a conidium. A vesicle, metulae and phialides forming a spherical conidial head, 30–33 µm diam.  Conidia ellipsoid to ovoid, occasionally globose, 1.5–3 × 1–2 µm.
Conidia ellipsoid to ovoid, occasionally globose, 1.5–3 × 1–2 µm.
Culture characteristics:
Colonies on PDA attaining a diam of 1 cm in 20 d at 25 °C, white, cottony; reverse pale brown, darkening with age towards the centre.
Colonies on PDA attaining a diam of 1 cm in 20 d at 25 °C, white, cottony; reverse pale brown, darkening with age towards the centre.
Reference:
Kuephadungphan W, Petcharad B, Tasanathai K, et al. (2022). Multi-locus phylogeny unmasks hidden species within the specialised spider-parasitic fungus, Gibellula (Hypocreales, Cordycipitaceae) in Thailand. Studies in Mycology101: 245–286.
DOI: https://doi.org/10.3114/sim.2022.101.04.Species |
Strain |
Compound |
Pubchem CID |
Biological activity |
Reference |
|---|
|
Strain |
ITS | LSU | RPB1 | TEF1 |
|---|---|---|---|---|
| BCC 45574 | OK040736 | OK040712 | OK040721 | OK040703 |